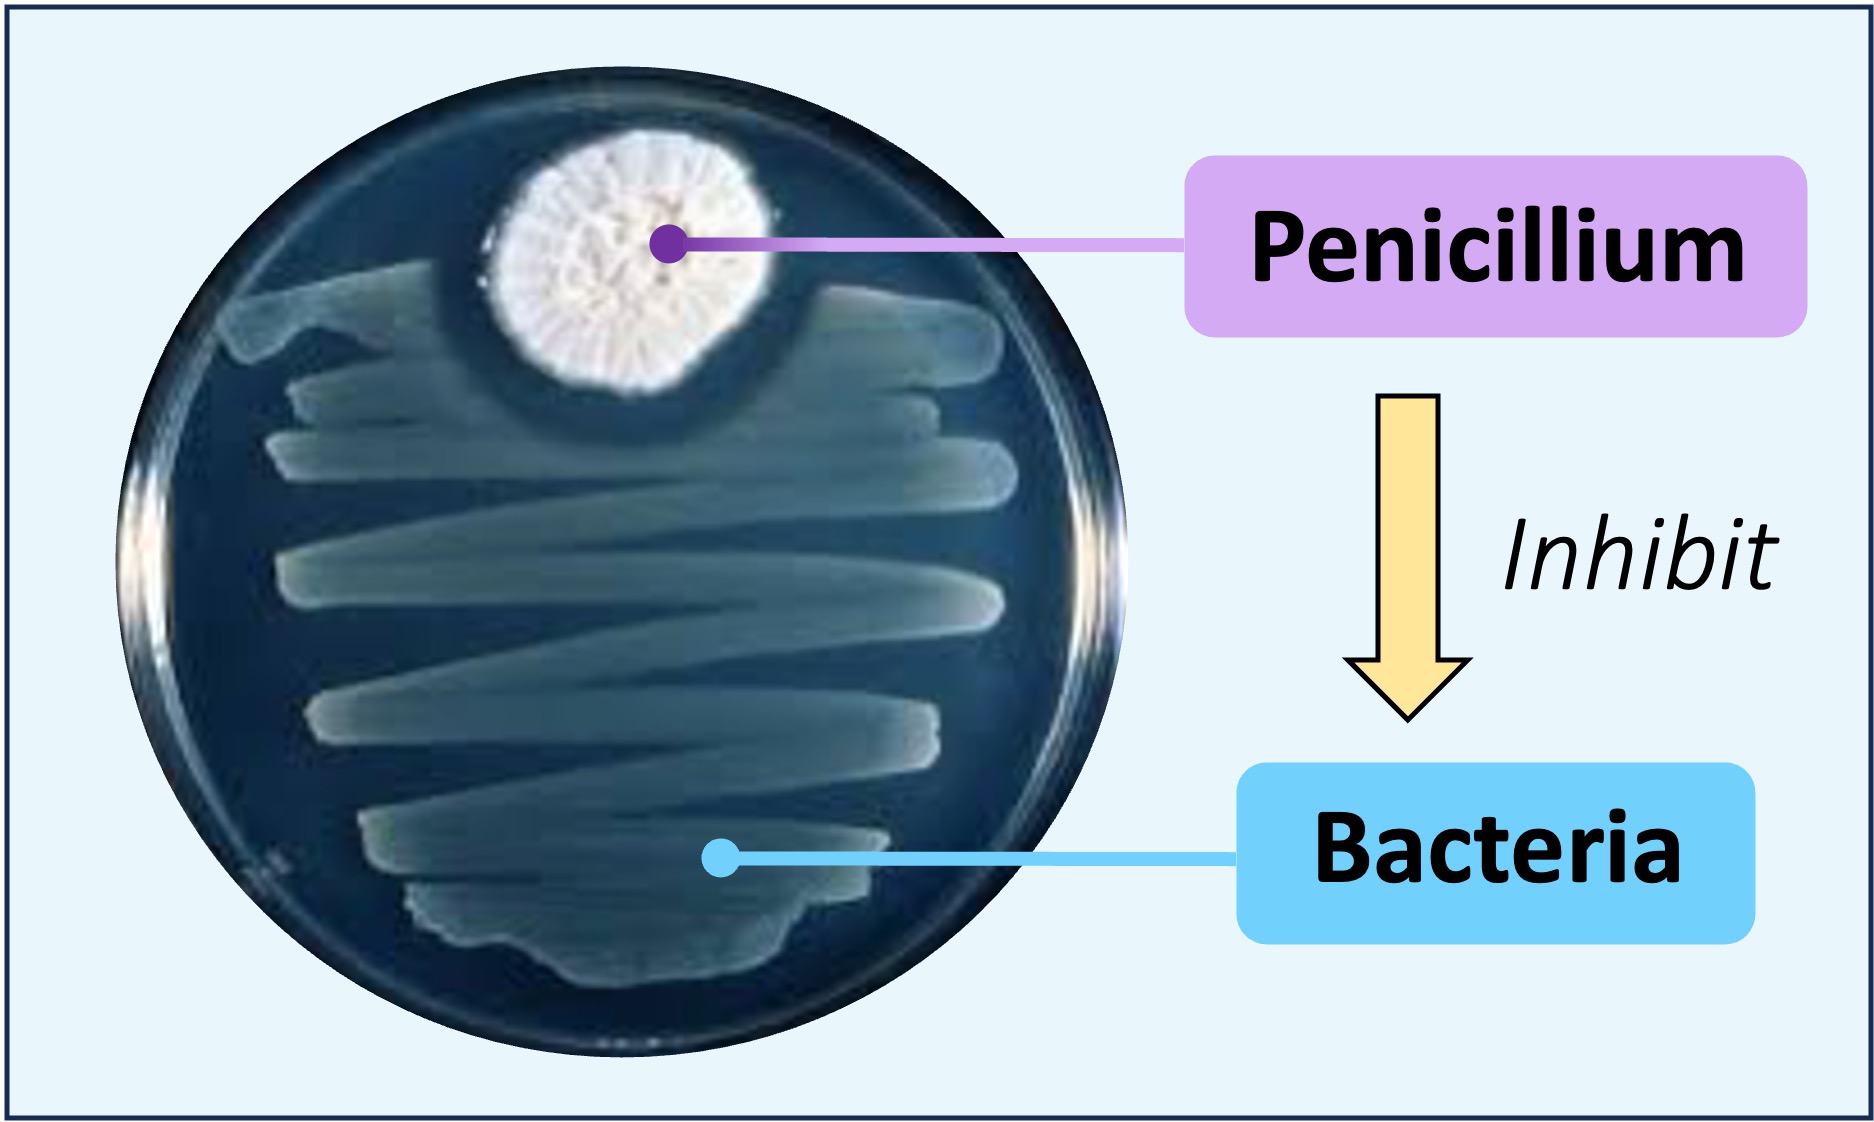
interaction6

Organisms within a species may be able to exert control over other species within a community by releasing chemicals called secondary metabolites
These are chemicals that are not essential for growth and are specific to certain groups of organisms
Two consequences of these chemical interactions are allelopathy and antibiotics
Allelopathy is a biological interaction whereby an organism releases chemicals that influence the growth, survival or reproduction of another organism
Allelopathic interactions can be positive (beneficial effects) or negative (detrimental effects) and predominantly involve plants
The chemicals can be released from the roots into the soil, via stomata into the air (as a gas) or be stored in leaves and released upon defoliation
An example is the release of a chemical called sinigrin by the garlic mustard plant, which reduces seed germination and root growth in other plant species
The secretion of antibiotics is a form of allelopathy whereby an organism releases chemicals that detrimentally impact bacteria
Antibiotics target prokaryotic cell features in order to either retard growth (bacteriostatic) or kill the bacterium (bactericidal)
An example is the release of penicillin from Penicillium (mould), which prevents cell wall formation in bacteria
Chemical Interactions

When an organism exerts control over other organisms with in community, it can have a top-down or a bottom-up effect
Limiting factors (such as nutrient availability) can also influence population growth via top-down and bottom-up control
Top down factors are pressures applied by a higher trophic level to control the population dynamics of the ecosystem
A higher order consumer either suppresses the abundance of its food source (by feeding) or alters the behaviour of competitiors to impact lower trophic levels
Top down control results in an oscillating trophic cascade (suppression at one level increases numbers at the next level)
Keystone species commonly exert top down control by preventing lower trophic levels from monopolising essential resources


Bottom up factors are pressures applied to lower trophic levels (e.g. producers) – such as the limited availability of resources
Suppression of a lower trophic levels impacts the abundance of organisms at higher trophic levels
Population growth will be reduced for all higher levels as the suppression of the 'bottom’ restricts energy supply to the ‘top'
Plant populations being limited by light intensity or phosphate levels in the soil are examples of bottom-up control


While it is possible for both types of control to operate at the same time, one or the other is likely to be dominant within a community
An aquatic ecosystem might be controlled by top-down feeding (herbivory by fish), but may switch to bottom-up control in the instance of an algal bloom (limiting light availability)